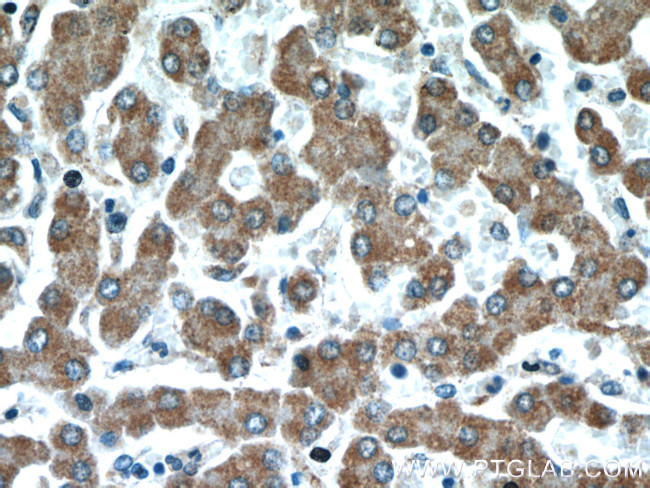
REDD1 Antibody in Immunohistochemistry (Paraffin) (IHC (P))

Search
Proteintech
REDD1 Polyclonal Antibody
{{$productOrderCtrl.translations['antibody.pdp.commerceCard.promotion.promotions']}}
{{$productOrderCtrl.translations['antibody.pdp.commerceCard.promotion.viewpromo']}}
{{$productOrderCtrl.translations['antibody.pdp.commerceCard.promotion.promocode']}}: {{promo.promoCode}} {{promo.promoTitle}} {{promo.promoDescription}}. {{$productOrderCtrl.translations['antibody.pdp.commerceCard.promotion.learnmore']}}
产品信息
10638-1-AP
种属反应
已发表种属
宿主/亚型
分类
类型
抗原
偶联物
形式
浓度
规格
纯化类型
保存液
内含物
保存条件
运输条件
产品详细信息
This antibody is a rabbit polyclonal antibody raised against full length human REDD1 antigen. This antibody is specific to the REDD1 from siRNA experiment.
Immunogen sequence: MPSLWDRFS SSSTSSSPSS LPRTPTPDRP PRSAWGSATR EEGFDRSTSL ESSDCESLDS SNSGFGPEED TAYLDGVSLP DFELLSDPED EHLCANLMQL LQESLAQARL GSRRPARLLM PSQLVSQVGK ELLRLAYSEP CGLRGALLDV CVEQGKSCHS VGQLALDPSL VPTFQLTLVL RLDSRLWPKI QGLFSSANSP FLPGFSQSLT LSTGFRVIKK KLYSSEQLLI EEC (1-232 aa encoded by BC007714)
靶标信息
DDIT4 gene ontology annotations related to this gene include cellular response to dexamethasone stimulus; intrinsic apoptotic signaling pathway in response to DNA damage by p53 class mediator; negative regulation of glycolytic process; negative regulation of TOR signaling; protein-containing complex disassembly; reactive oxygen species metabolic process; response to hypoxia.
仅用于科研。不用于诊断过程。未经明确授权不得转售。
生物信息学
蛋白别名: Dexamethasone-induced gene 2 protein; DNA damage-inducible transcript 4 protein; DNA-damage-inducible transcript 4 protein; evolutionarily conserved protein; HIF-1 responsive protein RTP801; HIF-1 responsive RTP801; hRTP801; Protein regulated in development and DNA damage response 1; REDD-1; RP11-442H21.1; unnamed protein product
基因别名: 5830413E08Rik; AA415483; DDIT4; Dig2; REDD-1; REDD1; RTP801
UniProt ID: (Human) Q9NX09, (Mouse) Q9D3F7
Entrez Gene ID: (Human) 54541, (Mouse) 74747